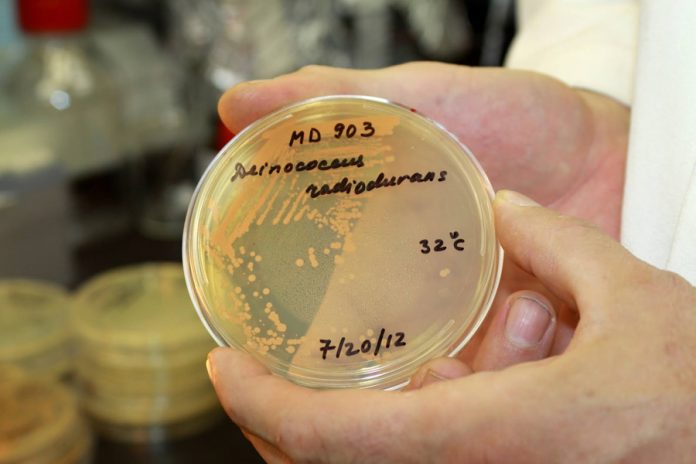

Një lloj bakteri i quajtur Deinococcus radiodurans dhe me pseudonimin “Bakteri Conan” ka veti të rezistojë edhe në ekstrem pasi duron rrezatim 28.000 herë më të fortë se sa ai që mund të vrasë njeriun. Sekreti i tij është i kyçur brenda një antioksidanti.
Shkencëtarët kanë zbërthyer mënyrën si antioksidanti funksionon duke treguar se në të ardhmen mund të përdoret për të mbrojtur shëndetin e njeriut, si në planetin Tokë ashtu edhe përtej. Antioksidanti përbëhet nga disa molekula të vogla që quhen metabolite në të cilat përfshihen mangani, fosfati dhe një peptid i vogël, DP1. E gjithë substanca bashkë njihet si MDP. Së bashku, kjo trilogji e fuqishme vepron në mbrojtjen ndaj rrezatimit, tregon një studim i ri i publikuar në Proceedings of the National Academy of Sciences.
Këto gjetje mund të përdoren për të mbrojtur astronautët nga dozat e larta të rrezatimit kozmik në misionet e hapësirës në sistemin tonë diellor.
“Ne e kemi ditur prej kohës që jonet e manganit dhe fosfatit bashkë janë një antioksidant i fuqishëm, por zbulimi dhe kuptimi i fuqisë ‘magjike’ të elementit të tretë është një hap i madh. Ky studim ka treguar pse ky kombinim është një mbrojtës rrezatimi kaq i fuqishëm dhe premtues”, tha bashkëautori Brian Hoffman.
Kjo mund të sjellë krijimin e antioksidantëve më të fuqishëm me bazë manganin dhe që mund të përdoren në shëndetësi, industri,ushtri dhe eksplorimin hapësinor. Duke qenë një mbrojtës i thjeshtë, jo i kushtueshëm, jo toksik dhe shumë efektiv, astronautët mund ta marrin edhe nga goja. Kështu mund të shmangin rreziqet e rrezatimit të lartë nga rrezet kozmike. Në Tokë, ai mund të përdoret për t’u mbrojtur ndaj aksidenteve që çlirojnë rrezatim.